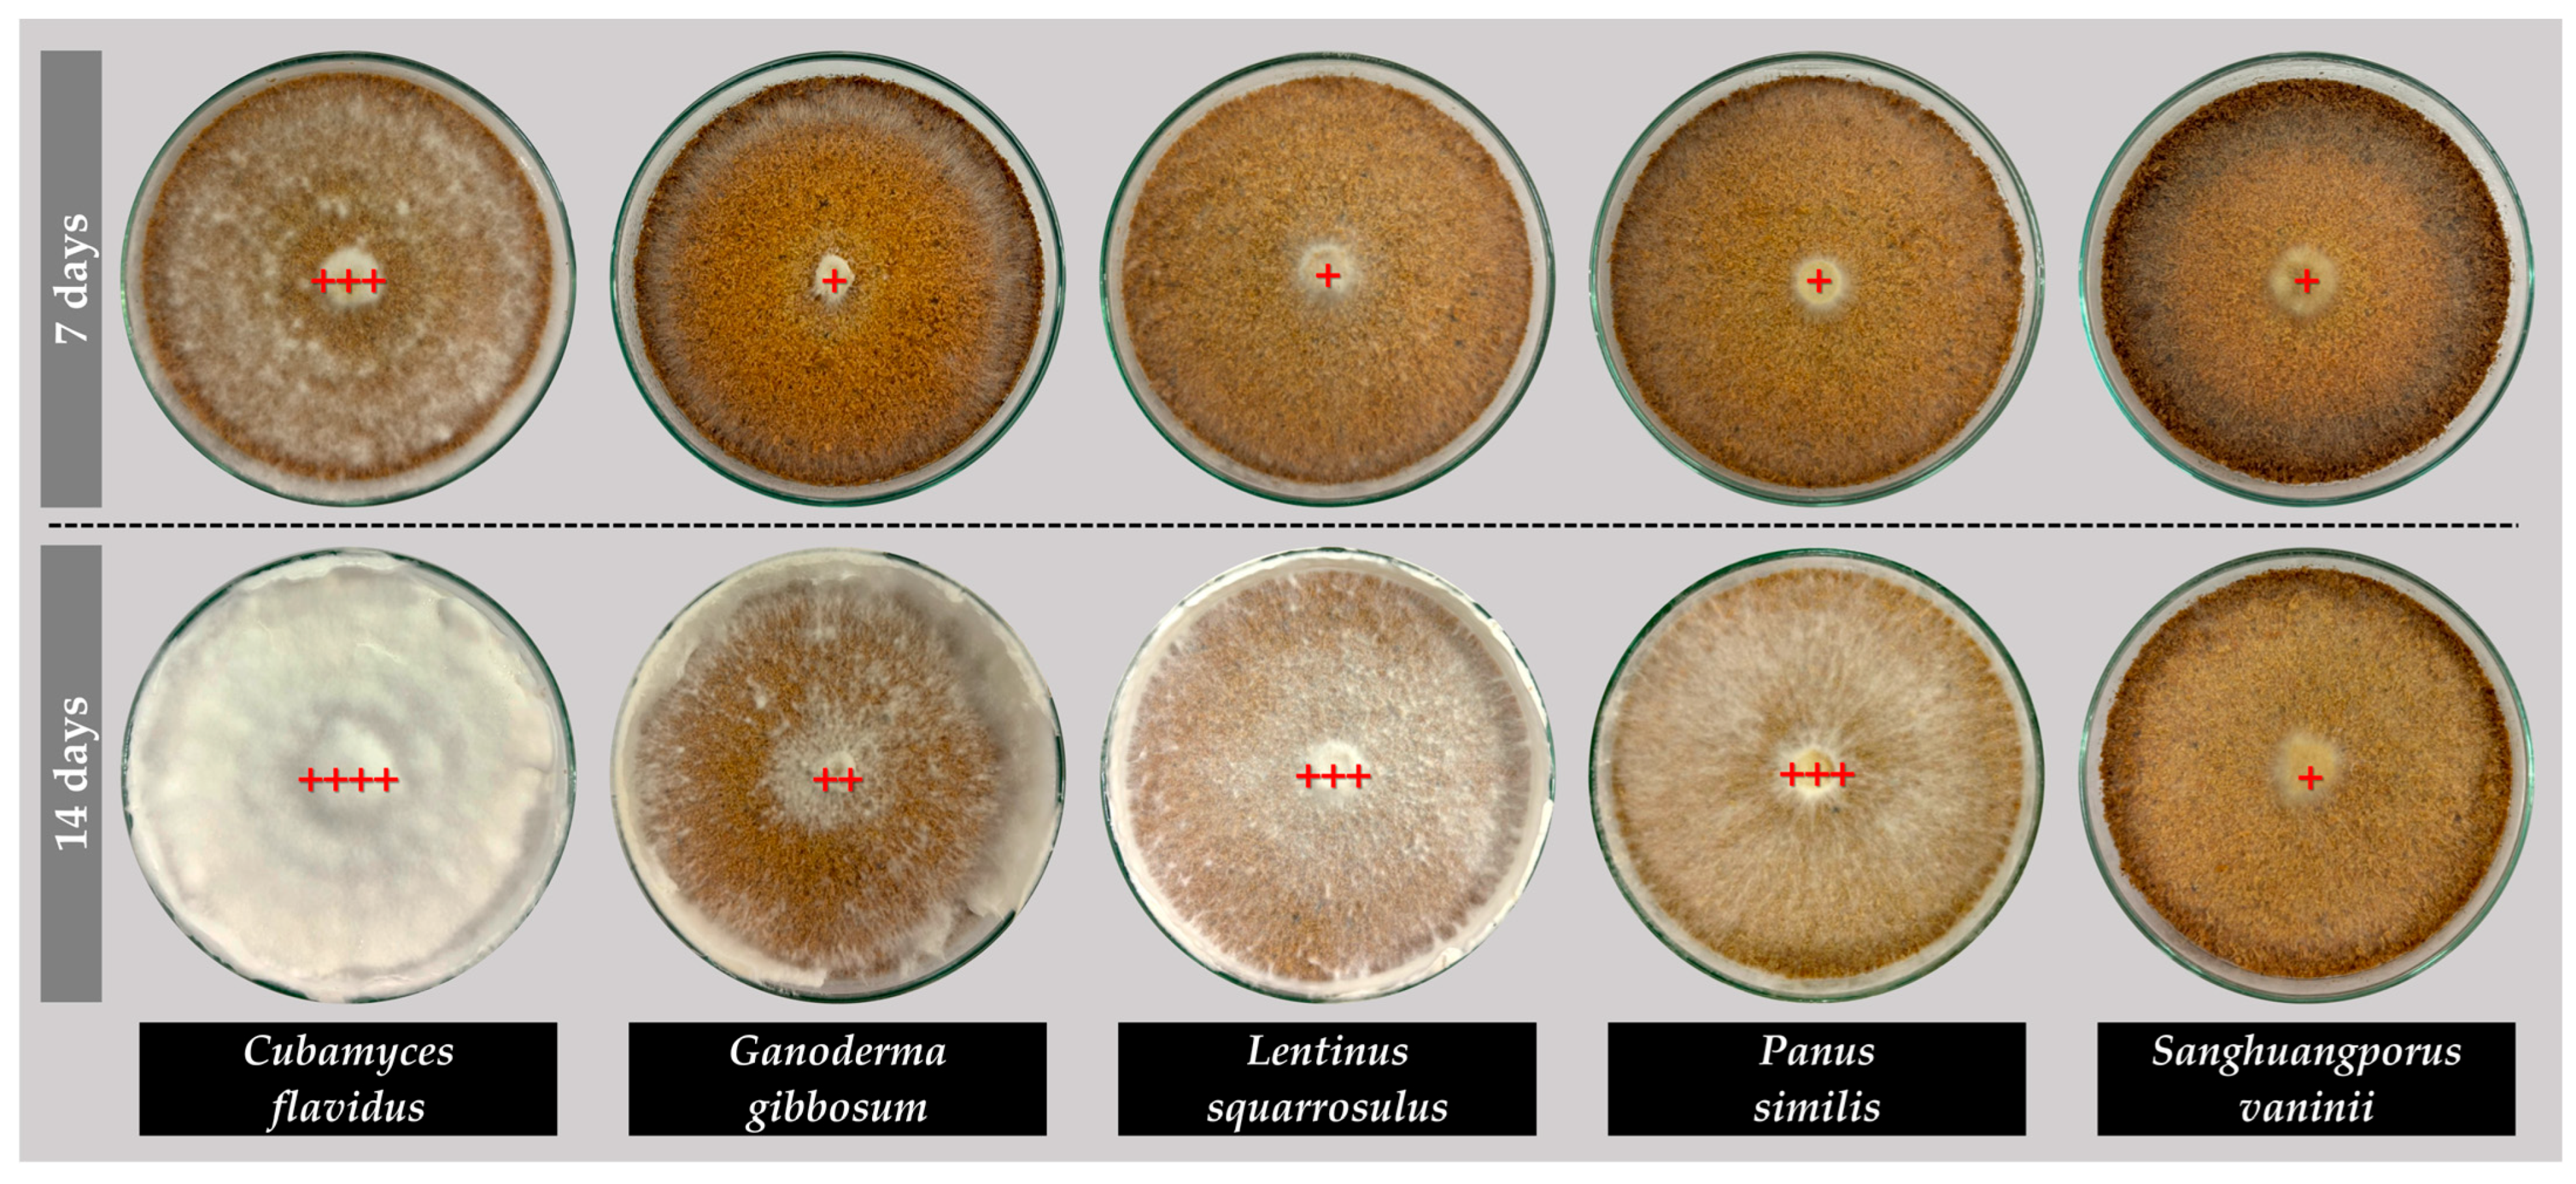
Life 15 01746 g004

Looking at the Possibility of Using Mushroom Mycelium for Developing Leather-like Materials Aligned with Eco-Friendly and Sustainable Fashion Trends
Abstract
1. Introduction
2. Materials and Methods
2.1. Source of Mushroom Mycelium and Inoculum Preparation
2.2. Substrate Use and Preparation
2.3. Measurement of Mycelial Development on Sawdust
2.4. Mushroom Mycelium Cultivation on Substrate
2.5. Induction of Mycelium-like Leather
2.6. Investigating the Physical Properties and Characteristics of Mycelium-like Leather
2.6.1. Assessing Visual Characteristics
2.6.2. Shrinkage and Density Measurements
2.6.3. Scanning Electron Microscope Observation
2.6.4. Water Absorption Testing
2.6.5. Thermogravimetric Analysis (TGA)
2.7. Statistical Analysis
3. Results and Discussion
3.1. Mycelial Growth Characteristics
3.2. Physical Properties and Characteristics
3.2.1. Visual Characteristics
3.2.2. Shrinkage and Density
| Species/Types | Shrinkage (%) | Thickness (mm) | Weight (g) | Density (g/cm3) |
|---|---|---|---|---|
| T1. Cubamyces flavidus | 24.09 ± 1.37 a | 1.29 ± 0.20 c | 0.42 ± 0.08 d | 0.13 ± 0.01 f |
| T2. Ganoderma gibbosum | 13.17 ± 3.39 c | 1.87 ± 0.26 b | 1.40 ± 0.18 b | 0.30 ± 0.02 c |
| T3. Lentinus squarrosulus | 21.44 ± 1.38 ab | 1.06 ± 0.05 c | 0.44 ± 0.04 d | 0.17 ± 0.02 e |
| T4. Panus similis | 22.68 ± 1.02 a | 0.50 ± 0.04 d | 0.17 ± 0.02 e | 0.14 ± 0.01 f |
| T5. Sanghuangporus vaninii | 18.96 ± 1.61 b | 1.76 ± 0.41 b | 0.92 ± 0.23 c | 0.21 ± 0.03 d |
| T6. Cow tanned leather | >5 [45] | 2.39 ± 0.05 a | 2.91 ± 0.12 a | 0.49 ± 0.02 a |
| T7. PU microfiber leather | 0.1–1.2 [46] | 1.06 ± 0.03 c | 1.02 ± 0.02 c | 0.38 ± 0.01 b |
3.3. Surface Structures of Mycelium-like Leather Sheets
3.4. Water Absorption
3.5. Thermogravimetric Analysis
3.6. Further Activities and Future Perspectives
4. Conclusions
Author Contributions
Funding
Institutional Review Board Statement
Informed Consent Statement
Data Availability Statement
Acknowledgments
Conflicts of Interest
References
- Gu, W. Research on strategy optimization of sustainable development towards green consumption of eco-friendly materials. J. King Saud. Univ. Sci. 2024, 36, 103190. [Google Scholar] [CrossRef]
- Kellen, C.; Zhafirah, L.; Kasih, T.P. Transforming fast fashion: Exploring bio-leather as a sustainable alternative. In Proceedings of the 8th International Conference on Eco Engineering Development, Semarang, Indonesia, 6–7 November 2025; IOP Conference Series: Earth and Environmental Science. p. 012039. [Google Scholar]
- Yorgancioglu, A.; Başaran, B.; Sancakli, A. Value Addition to Leather Industry Wastes and By-Products: Hydrolyzed Collagen and Collagen Peptides. In Waste in Textile and Leather Sectors; IntechOpen: London, UK, 2020; pp. 1–26. [Google Scholar]
- Sointukangas, K.; Pulkkis, N. Meet the Scientists of the Future Bioeconomy Part 5: Engineering Fungal Mycelium to Produce Leather Without Cows. Available online: https://www.bioeconomy.fi/meet-the-scientists-of-the-future-bioeconomy-part-5-geza-szilvay-is-engineering-fungal-mycelium-to-produce-leather-without-cows/ (accessed on 20 September 2025).
- Speranskaya, O. The Environmental Impact of Leather Production on Climate Change. Available online: https://sustainfashion.info/the-environmental-impact-of-leather-production-on-climate-change/ (accessed on 25 July 2025).
- Dhanda, V.; Arsalan, S.; Kaushal, S. Revolutionizing material: The rise of bio leather as eco-friendly and sustainable approach. Int. J. Agron. 2024, 7, 121–128. [Google Scholar] [CrossRef]
- Birlie, A.A. Transforming the leather industry: A comprehensive review on leather alternatives. J. Renew. Mater. 2025, 13, 1783–1802. [Google Scholar] [CrossRef]
- Shin, H.J.; Ro, H.S.; Kawauchi, M.; Honda, Y. Review on mushroom mycelium-based products and their production process: From upstream to downstream. Bioresour. Bioprocess. 2025, 12, 3. [Google Scholar] [CrossRef]
- Blundell, R. Innovative Mycelium Composites: Pioneering Sustainable Solutions. Available online: https://www.independent.com.mt/articles/2024-06-30/health/Innovative-mycelium-composites-Pioneering-sustainable-solutions-6736262323 (accessed on 25 July 2025).
- Crawford, A.; Miller, S.R.; Branco, S.; Fletcher, J.; Stefanov, D. Growing mycelium leather: A paste substrate approach with post-treatments. Res. Dir. Biotechnol. Des. 2024, 2, e6. [Google Scholar] [CrossRef]
- d’Errico, A.; Schröpfer, M.; Mondschein, A.; Safeer, A.A.; Baldus, M.; Wösten, H.A. Cross-linking impacts the physical properties of mycelium leather alternatives by targeting hydroxyl groups of polysaccharides and amino groups of proteins. Heliyon 2024, 10, e36263. [Google Scholar] [CrossRef]
- Raman, J.; Kim, D.S.; Kim, H.S.; Oh, D.S.; Shin, H.J. Mycofabrication of mycelium-based leather from brown-rot fungi. J. Fungi 2022, 8, 317. [Google Scholar] [CrossRef]
- Jones, M.; Gandia, A.; John, S.; Bismarck, A. Leather-like material biofabrication using fungi. Nat. Sustain. 2021, 4, 9–16. [Google Scholar] [CrossRef]
- Amobonye, A.; Lalung, J.; Awasthi, M.K.; Pillai, S. Fungal mycelium as leather alternative: A sustainable biogenic material for the fashion industry. Sustain. Mater. Technol. 2023, 38, e00724. [Google Scholar] [CrossRef]
- Elsacker, E.; Vandelook, S.; Peeters, E. Recent technological innovations in mycelium materials as leather substitutes: A patent review. Front. Bioeng. Biotechnol. 2023, 11, 1204861. [Google Scholar] [CrossRef] [PubMed]
- Akhter, S.; Jahan, M.S.; Rahman, M.L.; Ruhane, T.A.; Ahmed, M.; Khan, M.A. Revolutionizing sustainable fashion: Jute–mycelium vegan leather reinforced with polyhydroxyalkanoate biopolymer crosslinking from novel bacteria. Adv. Polym. Technol. 2024, 1, 1304800. [Google Scholar] [CrossRef]
- Verified Market Research. Mycelium Leather Market Size and Forecast. Available online: https://www.verifiedmarketresearch.com/product/mycelium-leather-market/ (accessed on 25 July 2025).
- Aiduang, W.; Suwannarach, N.; Kumla, J.; Thamjaree, W.; Lumyong, S. Valorization of agricultural waste to produce myco-composite materials from mushroom mycelia and their physical properties. Agric. Nat. Resour. 2022, 56, 1083–1090. [Google Scholar] [CrossRef]
- Teeraphantuvat, T.; Jatuwong, K.; Jinanukul, P.; Thamjaree, W.; Lumyong, S.; Aiduang, W. Improving the physical and mechanical properties of mycelium-based green composites using paper waste. Polymers 2024, 16, 262. [Google Scholar] [CrossRef] [PubMed]
- Aiduang, W.; Jatuwong, K.; Jinanukul, P.; Suwannarach, N.; Kumla, J.; Thamjaree, W.; Teeraphantuvat, T.; Waroonkun, T.; Oranratmanee, R.; Lumyong, S. Sustainable innovation: Fabrication and characterization of mycelium-based green composites for modern interior materials using agro-industrial wastes and different species of fungi. Polymers 2024, 16, 550. [Google Scholar] [CrossRef]
- Aiduang, W.; Kumla, J.; Srinuanpan, S.; Thamjaree, W.; Lumyong, S.; Suwannarach, N. Mechanical, physical, and chemical properties of mycelium-based composites produced from various lignocellulosic residues and fungal species. J. Fungi 2022, 8, 1125. [Google Scholar] [CrossRef]
- Reuters. Time for Fungus? Indonesian Watchmaker Turns to Mushroom Leather. Available online: https://www.reuters.com/article/lifestyle/time-for-fungus-indonesian-watchmaker-turns-to-mushroom-leather-idUSKBN1XA18U/ (accessed on 27 July 2025).
- Crawford, A. Species-specific mycelium growth pattern variations analysis for bio-design. In Proceedings of the International Conference on Research into Design, Bangalore, India, 9–11 January 2023; pp. 977–988. [Google Scholar]
- Kornerup, A.; Wanscher, J.H. Methuen Handbook of Colour, 3rd ed.; Eyre Methuen: London, UK, 1978; pp. 1–252. [Google Scholar]
- Christensen, C.M. Common Edible Mushrooms; The University of Minnesota Press: Minneapolis, MN, USA, 1972. [Google Scholar]
- Sharma, A.; Bhardwaj, G.; Nayik, G.A. (Eds.) Edible and Medicinal Mushrooms of the Himalayas: Climate Change, Critically Endangered Species, and the Call for Sustainable Development; CRC Press: Boca Raton, FL, USA, 2023. [Google Scholar]
- Ghobad-Nejhad, M.; Zhou, L.W.; Tomšovský, M.; Angelini, P.; Cusumano, G.; Angeles Flores, G.; Venanzoni, R.; Wang, X.W.; Chaharmiri-Dokhaharani, S.; Moridi, F.M.; et al. Unlocking nature’s pharmacy: Diversity of medicinal properties and mycochemicals in the family Hymenochaetaceae (Agaricomycetes, Basidiomycota). Mycosphere 2024, 15, 6347–6438. [Google Scholar] [CrossRef]
- Aiduang, W.; Jatuwong, K.; Luangharn, T.; Jinanukul, P.; Thamjaree, W.; Teeraphantuvat, T.; Waroonkun, T.; Lumyong, S. A review delving into the factors influencing mycelium-based green composites (MBCs) production and their properties for long-term sustainability targets. Biomimetics 2024, 9, 337. [Google Scholar] [CrossRef] [PubMed]
- Pahlawan, I.F.; Griyanitasari, G. Physico-mechanical properties of cattle hide leather for working gloves with flame retardant addition. Livest. Anim. Res. 2020, 2, 151–159. [Google Scholar] [CrossRef]
- ISO 2420:2017; Leather—Physical and Mechanical Tests—Determination of Apparent Density and Mass per Unit Area. International Organization for Standardization: Geneva, Switzerland, 2017.
- Zhang, Z.; Liu, Y.; Wang, J.; Xie, T.; Sun, L.; Li, Z. A chrome-free combination tanning strategy: Based on silicic acid and plant tannin. J. Leather Sci. Eng. 2021, 3, 15. [Google Scholar] [CrossRef]
- Kashyap, A.; Rawat, R.; Chandurkar, P.; Tripathi, N.; Choudhary, A.; Gurjar, N. Comparative study on the influence of culture type, substrate composition, and environmental conditions on mycelial growth of selected fungi. J. Mol. Sci. 2025, 35, 140–145. [Google Scholar]
- Globa, A.; Soh, E.; Le Ferrand, H. Living textures and mycelium skin co-creation: Designing colour, pattern, and performance for bio-aesthetic expression in mycelium-bound composites. Biomimetics 2025, 10, 573. [Google Scholar] [CrossRef]
- Srinivasarao, B.; Nagadesi, P.K. New records of wood decay fungi from Eastern Ghats of Andhra Pradesh, India. Saudi J. Pathol. Microbiol. 2021, 6, 451–459. [Google Scholar]
- Luangharn, T.; Karunarathna, S.C.; Dutta, A.K.; Paloi, S.; Promputtha, I.; Hyde, K.D.; Xu, J.; Mortimer, P.E. Ganoderma (Ganodermataceae, Basidiomycota) species from the greater Mekong subregion. J. Fungi 2021, 7, 819. [Google Scholar] [CrossRef] [PubMed]
- Ishaq, M.; Galappaththi, M.C.A.; Khan, M.B.; Ullah, S.; Fiaz, M.; Khalid, A.N. Lentinus squarrosulus an edible macro-fungus reported from Pakistan. Stud. Fungi 2022, 7, 6. [Google Scholar] [CrossRef]
- Yue, L.; Chen, J.; Tuo, Y.; Qi, Z.; Liu, Y.; He, X.L.; Zhang, B.; Hu, J.; Li, Y. Taxonomy and phylogeny of Panus (Polyporales, Panaceae) in China and its relationship with allies. MycoKeys 2024, 105, 267. [Google Scholar] [CrossRef]
- Shin, K.S. Identification of some Phellinus spp. Mycobiology 2001, 29, 190–193. [Google Scholar] [CrossRef]
- Balan, V.; Zhu, W.; Krishnamoorthy, H.; Benhaddou, D.; Mowrer, J.; Husain, H.; Eskandari, A. Challenges and opportunities in producing high-quality edible mushrooms from lignocellulosic biomass in a small scale. Appl. Microbiol. Biotechnol. 2022, 106, 1355–1374. [Google Scholar] [CrossRef] [PubMed]
- International Leather Club. Types of Leather: All Qualities, Grades, Finishes, & Cuts. Available online: https://www.internationalleatherclub.com/types-of-leather/?srsltid=AfmBOoqq8R-ObRu4zztf9HXqVZTxq3tSznaNnaDvkuozVxnpnP6o8kPF (accessed on 19 September 2025).
- Winiw. Understanding PU Leather: What It Is and How It’s Created. 2025. Available online: https://www.microfiberleather.com/th/content/understanding-pu-leather-created/ (accessed on 19 September 2025).
- Benetti, B.; Conti, F.; Dimitriadis, P. Mycelium-based leather: A review on post-processing treatments and material enhancements. Environ. Clim. Technol. 2025, 29, 390–404. [Google Scholar] [CrossRef]
- Angelova, G.; Yemendzhiev, H.; Zaharieva, R.; Brazkova, M.; Koleva, R.; Stefanova, P.; Baldzhieva, R.; Vladev, V.; Krastanov, A. Mycelium-based composites derived from lignocellulosic residual by-products: An insight into their physico-mechanical properties and biodegradation profile. Appl. Sci. 2025, 15, 6333. [Google Scholar] [CrossRef]
- Kuribayashi, T.; Lankinen, P.; Hietala, S.; Mikkonen, K.S. Dense and continuous networks of aerial hyphae improve flexibility and shape retention of mycelium composite in the wet state. Compos.-A Appl. Sci. Manuf. 2022, 152, 106688. [Google Scholar] [CrossRef]
- Zugno, L. Modern Cow Leather Processing. Available online: https://www.leathernaturally.org/wp-content/uploads/2023/02/LN-Guide_to_leather_making_PART_TWO.pdf (accessed on 15 August 2025).
- Krusetraining. Polymer Shrinkage. Available online: https://krusetraining.com/mandarin/wp-content/uploads/sites/3/2017/10/Polymer-Shrinkage.pdf (accessed on 15 August 2025).
- Kelly, S.J.R.; Weinkamer, R.; Bertinetti, L.; Edmonds, R.L.; Sizeland, K.H.; Wells, H.C.; Fratzl, P.; Haverkamp, R.G. Effect of collagen packing and moisture content on leather stiffness. J. Mech. Behav. Biomed. Mater. 2019, 90, 1–10. [Google Scholar] [CrossRef]
- Karunarathne, A.; Nabiyeva, G.; Rasmussen, C.J.; Alkhoury, K.; Assem, N.; Bauer, J.; Chester, S.A.; Khalizov, A.F.; Gor, G.Y. Effects of humidity on mycelium-based leather. ACS Appl. Bio Mater. 2024, 7, 6441–6450. [Google Scholar] [CrossRef] [PubMed]
- Hao, Y.; Wang, H.; Tian, D.; Zhang, W.; Shi, B. Scalable production of robust, moisture-wicking, and breathable superfine mycelium fiber/waterborne polyurethane leather-like textile via direct casting and oven-drying. Ind. Crops Prod. 2025, 226, 120632. [Google Scholar] [CrossRef]
- Smith, J. What is Microfiber Leather? Available online: https://leatherskinshop.com/blogs/default-blog/what-is-microfiber-leather-1 (accessed on 17 September 2025).
- Parhizi, Z.; Dearnaley, J.; Kauter, K.; Mikkelsen, D.; Pal, P.; Shelley, T.; Burey, P.P. The fungus among us: Innovations and applications of mycelium-based composites. J. Fungi 2025, 11, 549. [Google Scholar] [CrossRef] [PubMed]
- Kohphaisansombat, C.; Jongpipitaporn, Y.; Laoratanakul, P.; Tantipaibulvut, S.; Euanorasetr, J.; Rungjindamai, N.; Chuaseeharonnachai, C.; Kwantong, P.; Somrithipol, S.; Boonyuen, N. Fabrication of mycelium (oyster mushroom)-based composites derived from spent coffee grounds with pineapple fibre reinforcement. Mycology 2024, 15, 665–682. [Google Scholar] [CrossRef] [PubMed]
- Sun, W.; Tajvidi, M.; Howell, C.; Hunt, C.G. Insight into mycelium-lignocellulosic bio-composites: Essential factors and properties. Compos.-A Appl. Sci. Manuf. 2022, 161, 107125. [Google Scholar] [CrossRef]
- Daâssi, D.; M Alhumairi, A.; Mellah, B.; Fdhil, N.; Baccar, N.; Chamkha, M. Physico-mechanical, thermal, and biodegradation performance of mycelium biocomposites derived from residual agrowastes. Polym. Bull. 2025, 82, 11295–11321. [Google Scholar] [CrossRef]
- Olivero, E.; Gawronska, E.; Manimuda, P.; Jivani, D.; Chaggan, F.Z.; Corey, Z.; de Almeida, T.S.; Kaplan-Bie, J.; McIntyre, G.; Nalam, P.C. Gradient porous structures of mycelium: A quantitative structure–mechanical property analysis. Sci. Rep. 2023, 13, 19285. [Google Scholar] [CrossRef]
- Appels, F.V.; van den Brandhof, J.G.; Dijksterhuis, J.; de Kort, G.W.; Wösten, H.A. Fungal mycelium classified in different material families based on glycerol treatment. Commun. Biol. 2020, 3, 334. [Google Scholar] [CrossRef]
- Elsacker, E.; Zhang, M.; Dade-Robertson, M. Fungal engineered living materials: The viability of pure mycelium materials with self-healing functionalities. Adv. Funct. Mater. 2023, 33, 2301875. [Google Scholar] [CrossRef]
- Chulikavit, N.; Huynh, T.; Dekiwadia, C.; Khatibi, A.; Mouritz, A.; Kandare, E. Influence of growth rates, microstructural properties and biochemical composition on the thermal stability of mycelia fungi. Sci. Rep. 2022, 12, 15105. [Google Scholar] [CrossRef] [PubMed]
- Kniep, J.; Graupner, N.; Reimer, J.J.; Müssig, J. Mycelium-based biomimetic composite structures as a sustainable leather alternative. Mater. Today Commun. 2024, 39, 109100. [Google Scholar] [CrossRef]
- Lasoń-Rydel, M.; Sieczyńska, K.; Gendaszewska, D.; Ławińska, K.; Olejnik, T.P. Use of enzymatic processes in the tanning of leather materials. AUTEX Res. J. 2024, 24, 20230012. [Google Scholar] [CrossRef]
- Laveri. Why Leather Bags Attract Dust—And How to Keep Them Clean Longer. Available online: https://mylaveri.com/blogs/news/why-leather-bags-attract-dust-and-how-to-keep-them-clean-longer?srsltid=AfmBOoqHiz-Rmp1qaNRkThe2-H6wbJzbGoygwp90PFfaHCJSYqODoxuB (accessed on 20 September 2025).

| Species/Types | Sheet Characteristics |
|---|---|
| T1. Cubamyces flavidus | Type of mushroom: Medicinal Decay type of mushroom: White rot Hyphal system: Trimitic Color and texture: Whitish to Yellowish Shades: Ranging from mostly and yellowish white to light yellow (4A2–4), often grayish yellow (4B4–6), and somewhere pale to light orange (5A3–4). The surface is mostly smooth, though scattered primordia-like bumps provide slight inconsistencies in texture. |
| T2. Ganoderma gibbosum | Type of mushroom: Medicinal Decay type of mushroom: White rot Hyphal system: Trimitic Color and texture: Warm Orange to Deep Brown Tones: Various in color from whitish and orange-white hues, progressing to light orange (5A2–5), reddish golden to brownish orange (6C3–4), light brown (6D4–5) to brown (7E4–8), and even reddish to dark brown (8F4–8). The surface is mostly rough, with certain distinctly coarse areas. |
| T3. Lentinus squarrosulus | Type of mushroom: Edible Decay type of mushroom: White rot Hyphal system: Dimitic Color and texture: Orange-White to Dark Earthy Colors: Ranging from whitish and pale orange (5A2–3) to brown (7E3–7), dark brown (7F5–8), and brownish gray (7C2). The entire sheet has a consistently rough, hard texture that gives it a rugged appearance. |
| T4. Panus similis | Type of mushroom: Medicinal Decay type of mushroom: White rot Hyphal system: Dimitic Color and texture: Orange-White to Rich Brown Gradient: Featuring whitish, orange-white, light orange (5A2–4), grayish orange (5B3–4, 6B3–5), light brown (6D4–5), and brown (6E6). The sheet’s surface is largely smooth and uniform, with only minor roughness in small areas. |
| T5. Sanghuangporus vaninii | Type of mushroom: Medicinal Decay type of mushroom: White rot Hyphal system: Dimitic Color and texture: Light brown (6D5–8), brown to dark brown (6F7–8). The surface is smooth throughout, with a few slightly rough sections giving some textural variation. |
| T6. Cow tanned leather | Color and texture: Warm Brownish Orange Palette: Dominated by brownish orange (6C8) and deep brown (6D8). The surface is consistently smooth, giving it a refined, cleaned appearance. |
| T7. Polyurethane microfiber leather | Color and texture: Deep Chocolate Browns: Transitioning from brown (7E8) to dark brown (8E7–8). The sheet exhibits an exceptionally smooth and uniform surface, providing it a refined, polished look. |
Disclaimer/Publisher’s Note: The statements, opinions and data contained in all publications are solely those of the individual author(s) and contributor(s) and not of MDPI and/or the editor(s). MDPI and/or the editor(s) disclaim responsibility for any injury to people or property resulting from any ideas, methods, instructions or products referred to in the content. |
© 2025 by the authors. Licensee MDPI, Basel, Switzerland. This article is an open access article distributed under the terms and conditions of the Creative Commons Attribution (CC BY) license (https://creativecommons.org/licenses/by/4.0/).
Share and Cite
Aiduang, W.; Patipattanakul, T.; Keduk, Y.; Rattanapat, A.; Phumila, P.; Jinanukul, P.; Sysouphanthong, P.; Xayyavong, O.; Jatuwong, K.; Lumyong, S. Looking at the Possibility of Using Mushroom Mycelium for Developing Leather-like Materials Aligned with Eco-Friendly and Sustainable Fashion Trends. Life 2025, 15, 1746. https://doi.org/10.3390/life15111746
Aiduang W, Patipattanakul T, Keduk Y, Rattanapat A, Phumila P, Jinanukul P, Sysouphanthong P, Xayyavong O, Jatuwong K, Lumyong S. Looking at the Possibility of Using Mushroom Mycelium for Developing Leather-like Materials Aligned with Eco-Friendly and Sustainable Fashion Trends. Life. 2025; 15(11):1746. https://doi.org/10.3390/life15111746
Chicago/Turabian StyleAiduang, Worawoot, Thanawin Patipattanakul, Yutthaphum Keduk, Apiwit Rattanapat, Phumin Phumila, Praween Jinanukul, Phongeun Sysouphanthong, Orlavanh Xayyavong, Kritsana Jatuwong, and Saisamorn Lumyong. 2025. "Looking at the Possibility of Using Mushroom Mycelium for Developing Leather-like Materials Aligned with Eco-Friendly and Sustainable Fashion Trends" Life 15, no. 11: 1746. https://doi.org/10.3390/life15111746
APA StyleAiduang, W., Patipattanakul, T., Keduk, Y., Rattanapat, A., Phumila, P., Jinanukul, P., Sysouphanthong, P., Xayyavong, O., Jatuwong, K., & Lumyong, S. (2025). Looking at the Possibility of Using Mushroom Mycelium for Developing Leather-like Materials Aligned with Eco-Friendly and Sustainable Fashion Trends. Life, 15(11), 1746. https://doi.org/10.3390/life15111746

